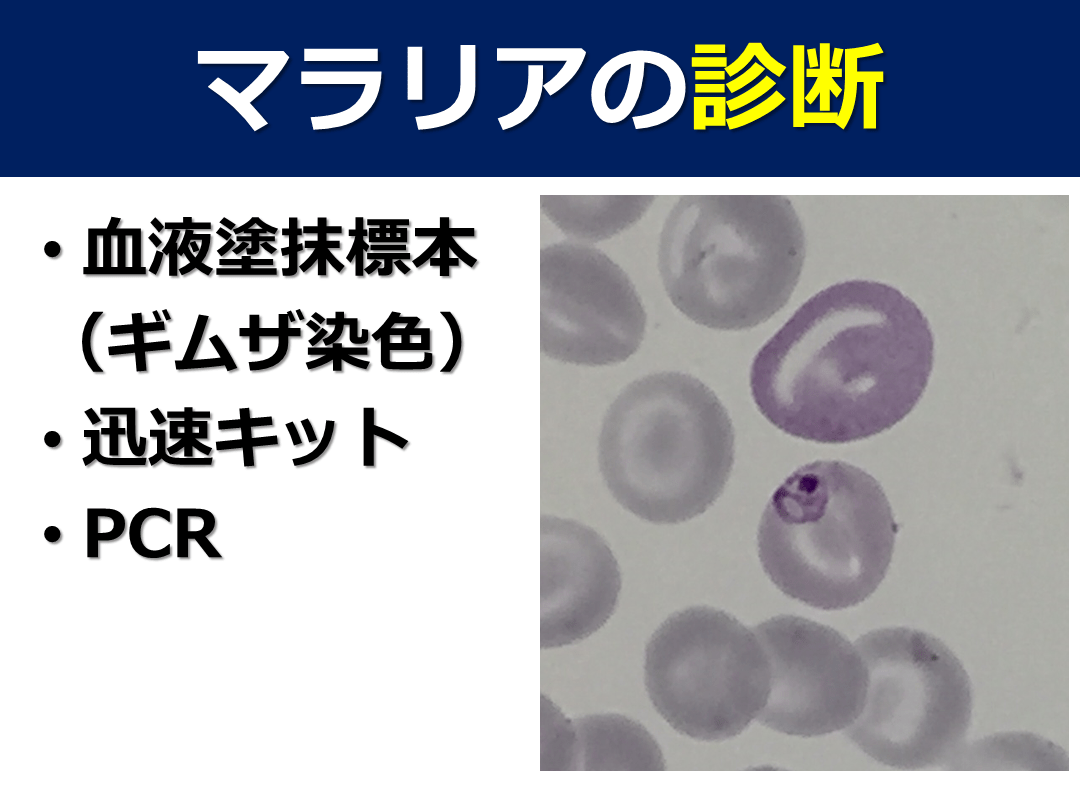

1/301
関連するスライド
COVID-19の感染伝播リスクと隔離解除 update(2021.3)
黒田浩一
63708
39
グラム陽性球菌
UkaiKohei
130197
336
感染症診療の基本的な考え方 -血液培養とその界隈-
高野哲史
46157
289
細菌性髄膜炎のマネジメント
長谷川耕平
103230
206
アフリカにおける感染症対策
72,756
48
概要
主にアフリカなどの熱帯地方における重要な感染症について、疫学・症状・治療などについてまとめました。基本的に、医療関係者ではない人向けに作成したものですので、輸入感染症・熱帯地方での感染症についての導入に役立てていただければ幸いです。
本スライドの対象者
専攻医/専門医
投稿された先生へ質問や勉強になったポイントをコメントしてみましょう!
0 件のコメント
黒田浩一さんの他の投稿スライド
市中肺炎診療の考え方 ウィズコロナ時代
黒田浩一
573,053
409
免疫抑制・化学療法によるB型肝炎ウイルス再活性化への対策
黒田浩一
36,729
285
COVID-19治療 アップデート 2023年9月版
黒田浩一
1,090,092
1,010
このスライドと同じ診療科のスライド
テキスト全文
アフリカにおける感染症対策の概要
#1.
アフリカにおける感染症対策 亀田総合病院感染症科 黒田浩一 2018.10
#2.
本日の内容 Introduction –海外と日本人- 海外で問題となる健康問題 –総論- 情報収集方法 アフリカで問題となる感染症とその対策
日本人海外旅行者と健康問題の現状
#3.
Introduction 海外と日本人
#4.
日本人海外旅行者数
#5.
2017年 1788万9300人 日本政府観光局(JNTO)のHPから(推計値) https://www.jnto.go.jp/jpn/statistics/data_info_listing/pdf/180116_monthly.pdf
#6.
訪日外国人旅行者
#7.
2017年 2869万1073人 日本政府観光局のHPから https://www.jnto.go.jp/jpn/statistics/since2003_tourists.pdf
#8.
海外在留邦人数
#9.
定義 在留邦人 海外に3か月以上在留している日本国籍を有する者 長期滞在者 海外での生活は一時的で、いずれ帰国予定の邦人 永住者 当該在留国等より永住権を認められており、生活の本拠を 日本から海外へ移した邦人
#10.
2017年 135万1970人 日本の人口の約1.1% 外務省のHPから https://www.mofa.go.jp/mofaj/files/000394748.pdf
発展途上国滞在時の健康問題と感染症リスク
#11.
・長期滞在者 ・永住者 ともに年々増加傾向 ・過去5年間で 約7.4%の増加 (9万人以上)
#12.
ほとんどが先進国と東アジア
#13.
海外で問題となる健康問題(感染症とは限らない)
#14.
10万人あたり なんらかの健康問題 5-6万人 (体調不良 or 薬剤の内服) 体調不良を自覚 2-3万人 医療機関受診 or 帰国 8000人 帰国後の就労困難 300人 飛行機で搬送 60人 死亡 1人 1ヶ月間発展途上国に滞在した場合の健康問題 Int J Antimicrob Agents 2003;21:89-95
#15.
1ヶ月間発展途上国に滞在した場合の感染症罹患リスク J Travel Med 2008;15(3):145-6 旅行者下痢症:20-60% マラリア:2-3%(予防-) インフルエンザ:1% デング熱:1% 動物咬傷(狂犬病リスク):0.5% A型肝炎:0.03% 腸チフス:0.02% 日本脳炎:0.0001%
海外感染症情報収集の方法とリソース
#16.
発展途上国から帰国後に病院を受診する患者の主訴 1:発熱 2:下痢 3:皮膚症状 N Engl J Med 2006;354:119-30
#17.
頻度の多い発熱の原因 約50%が診断がつく(病原体が判明) マラリア デング熱 伝染性単核症 リケッチア enteric fever(腸チフス・パラチフス) N Engl J Med 2006;354:119-30
#18.
海外の感染症についてどのように情報収集する?
#19.
地域の流行疾患に関する情報源 厚生労働省検疫所(FORTH) http://www.forth.go.jp/ CDC Travelers’ Health http://wwwnc.cdc.gov/travel/ Fit for Travel http://www.fitfortravel.nhs.uk/home.aspx WHOのHomepage, ProMED-mail
#20.
Googleを活用する
CDC Travelers’ Healthと感染症予防情報
#21.
厚生労働省検疫所(FORTH)
#22.
「FORTH 感染」「FORTH 渡航」でもOKです
#23.
-
#24.
厚生労働省検疫所(FORTH)
#25.
例:アンゴラの感染症の流行状況を調べる場合
#26.
-
#27.
-
#28.
-
#29.
CDC Travelers’ Health 情報量が多い わかりやすい ただし英語
#30.
CDC Travelers’ Health 渡航先別(国別)に - 必要な渡航前のワクチン一覧 - ワクチンでは予防できない感染症の一覧 各感染症の詳細 感染予防策 について、わかりやすく記載されている
アフリカでの感染症の種類と対策
#31.
検索はGoogleで
#32.
-
#33.
-
#34.
目的地
#35.
旅行者向け 医療者向け こちらの方が詳しい
#36.
渡航先を選択 ここは選択不要 Goをクリック
#37.
旅行者向け
#38.
接種が推奨されるワクチン その疾患のその他の予防法
#39.
-
#40.
医療者向け
マラリアの疫学、症状、診断、治療法
#41.
推奨されるワクチンとその疾患について
#42.
-
#43.
ワクチンで予防できない感染症 この項目は「旅行者向け」にはない
#44.
渡航者への教育(情報提供)
#45.
Fit for Travel
#46.
Fit for Travel 内容は、CDCのTravelers’ Healthと同様 マラリア流行状況がわかりやすい! Malaria Mapを利用しましょう
#47.
再びGoogleを活用
#48.
fit for travel malaria map 国名(例えばAngola) で検索すると...
#49.
国名は、カタカナでも検索できます
#50.
-
#51.
-
#52.
ProMED-mail the Program for Monitoring Emerging diseases International society for infectious diseaseによって運営されている新興感染症などをモニタリングするためのプログラム(メーリングリスト) 毎日世界中で起きている感染症のアウトブレイクや研究がupdateされる 情報の迅速性に優れるが、時に間違った情報が流れることもある
#53.
アフリカで問題となる感染症
#54.
サハラ以南アフリカ 他地域と比較して熱帯熱マラリアが圧倒的に多い 一部地域ではエボラウイルスの流行が問題となった リケッチア、ジアルジア、糞線虫などにも注意が必要 ill travelersにおける原因が特定された各疾患の頻度 Ann Intern Med 2013;158:456-468
#55.
サハラ以南アフリカで発熱したら... まず熱帯熱マラリアを考える
#56.
サハラ以南アフリカで問題となる感染症 コレラ A型肝炎 B型肝炎 マラリア 狂犬病 腸チフス 黄熱 髄膜炎菌 ジカウイルス デング熱 チクングニア熱 アフリカダニ熱 アフリカ睡眠病 ペスト 住血吸虫 など
黄熱とその流行状況、予防接種の重要性
#57.
感染経路別で分類する
#58.
感染経路別分類 蚊、ダニ、ハエ、ノミ マラリア、黄熱、ジカウイルス、デング熱 チクングニア熱、アフリカダニ熱、アフリカ睡眠病、ペスト 水・食事 コレラ、A型肝炎、腸チフス、ポリオ、アメーバ赤痢 動物 狂犬病、鳥インフルエンザ、破傷風 性交渉 B型肝炎、HIV、アメーバ赤痢 ヒト-ヒト感染(飛沫感染・空気感染) 髄膜炎菌、結核、肺ペスト、麻疹、風疹 淡水との接触 住血吸虫、レプトスピラ
#59.
蚊媒介感染症
#60.
蚊媒介感染症 マラリア 黄熱 ジカウイルス デング熱 チクングニア熱
#61.
マラリア
#62.
マラリアの分類 - 熱帯熱マラリア(Plasmodium falciparum) 最多、もっとも重症 世界中に分布するが、サハラ以南アフリカに多い - 三日熱マラリア(P. vivax) 2番目に多い、アジア・南米・オセアニア - 卵形マラリア(P. ovale) 世界中に分布、主にアフリカと東南アジア、少ない - 四日熱マラリア(P. malariae) 世界中に分布、少ない - サルマラリア(P. knowlesi) マレーシアなどの東南アジア Lancet 2018;391:1608–21
#63.
疫学 2億1600万人が感染(2016年) そのほとんどがサハラ以南アフリカ(1億9000万人程度) 約44万5000人が死亡(2016年) 2000年から2015年にかけて年間発症数は18%減少した(2015年→2016年は増加) http://www.who.int/malaria/en/
#64.
マラリア感染のリスクがある地域
#65.
World Malaria Report 2017, WHO 青:ここ3年以上発症のない国
#66.
生活環 蚊→ヒト→蚊→ヒト
#67.
症状 発熱、頭痛、悪寒、筋肉痛、嘔吐、下痢などの非特異的症状 - 「インフルエンザ様」、特徴のない「発熱と体調不良」 →症状のみからの診断は難しい マラリア流行地への渡航歴がとても重要 潜伏期間 - 熱帯熱マラリア:10-14日(7-30日) - 三日熱マラリア:2-3週間
#68.
熱帯熱マラリアは診断・治療が遅れると重症化する
#69.
重症マラリア 意識障害 痙攣 虚弱 低血糖 著明な貧血 腎不全 呼吸状態悪化 血圧低下 死亡率が高い!
#70.
サハラ以南アフリカで発熱 病院でマラリアチェック
腸チフス、A型肝炎、コレラの感染経路と予防
#71.
マラリア流行地域滞在者の発熱そうでないとわかるまでマラリアとして対応する
#72.
マラリアの診断 血液塗抹標本 (ギムザ染色) 迅速キット PCR
#73.
マラリアの治療 重症の熱帯熱マラリア キニーネ(点滴) ※日本では、アテースネートが使用できない その他 リアメット(アルテメテル・ルメファントリン) マラロン(アトバコン・プログアニル) 三日熱マラリア・卵形マラリア プリマキン(G6PD活性がある場合)を追加
#74.
予防 ABCD approach - Awareness of risk - Bite Prevention (ハマダラカ対策) - Chemoprophylaxis (抗マラリア薬予防内服) - Diagnosis and prompt treatment Fit For Travel. https://www.fitfortravel.nhs.uk/advice/malaria
#75.
A:リスクを認識する マラリア流行地域 にいることを認識する
#76.
B:防蚊対策 蚊が多い時間・場所を避ける - 日没以降、農村部、水のあるところ 長袖・長ズボン 防虫剤(DEET含有) 蚊帳を使用する(殺虫剤含有)
#77.
蚊 ハマダラカ:夕暮れから夜明けに活動 マラリア ヤブカ:日中に活動 デング ヒトスジシマカ・ネッタイシマカ チクングニア ヒトスジシマカ・ネッタイシマカ ジカ ヒトスジシマカ・ネッタイシマカ 黄熱 ネッタイシマカ など
#78.
防虫剤(虫よけ) DEET N,N-diethyl-3-methylbenzamide イカリジン(Picaridin)
#79.
DEET含有防虫剤 蚊、ダニ、ハエ、ノミなどに効果がある 昆虫忌避薬のGold Standard 10-35%を通常使用(CDCは20%以上を推奨) DEETの濃度は、効果の持続時間と関連する - 10%で2時間の効果 - 24%で5時間の効果 - 30%で6時間の効果 - 50%で12時間の効果(ここで頭打ち)
#80.
DEET含有防虫剤 生後2か月以上から使用可能(CDC) 妊婦にも使用可能(CDC) 露出した皮膚に塗る 服にスプレーしてもよい 直接顔にスプレーせずに、手にとってから顔に塗る 水溶性のため、水泳や発汗後は、塗りなおす 日焼け止めを使用する場合は、日焼け止めを使用した後に塗る
#81.
日本のDEET含有防虫剤 DEET 12%含有 DEET 30%含有
#82.
日本の製品のルール 小児にはDEET12%製剤を使用 - 6か月未満には使用不可 - 6か月以上2歳未満:1日1回まで - 2歳以上12歳未満:1日3回まで
#83.
イカリジン イカリジン20%とDEET 20%が同等(Fit For Travel) 蚊、ダニなどに効果あり ダニへの効果はDEETより劣るかもしれない DEET含有製剤のほうが持続時間が長い 基本的に、DEET配合剤を優先 年齢制限なし イカリジン 15%
#84.
C:抗マラリア薬予防内服 マラロン® (アトバコン・プログアニル) メフロキン ドキシサイクリン のいずれかを使用する
#85.
D:診断と早期治療 24時間以内に急激に悪化することがある 症状は非特異的 予防内服していても罹患することはある 疑ったら、すぐに医療機関を受診する
#86.
黄熱
#87.
黄熱 フラビウイルス属 黄熱ウイルス サハラ以南アフリカと中南米で流行 - 正確なサーベイランスデータはない 主な宿主は、サル・ヒト・蚊 ネッタイシマカなどによって媒介される - アフリカ:Aedes 属(ネッタイシマカ)が多い - 南米:Haemagogus 属が多い ヒト-ヒト感染はしない 約15%が重症化する
#88.
アフリカ CDC. Yellow Book 2018. アンゴラ ガーナ
#89.
中南米 最新版 最新版(2018.5.5) ・サンパウロ市 ・リオデジャネイロ市 などの都市部も、ワクチン接種推奨地域に含まれた CDC. Yellow Book 2018.
#90.
流行時期 アフリカ - 雨季の後半からは乾季の前半 - 西アフリカ:通常7月から10月 中南米 - 雨季(1-5月:ピークは2-3月)
#91.
アンゴラでのoutbreak 2015年12月5日にルアンダ州Vianaで1例目が確認された 都市部でのoutbreak 隣国のコンゴ民主共和国へも拡がりoutbreakした 終息宣言 - 2016年12月23日 アンゴラ - 2017年2月14日 コンゴ民主共和国 2か国で確定965例、疑い患者は7000人以上 2か国で3000万人以上がワクチン接種を受けた 中国、ケニアでも、黄熱の輸入症例があった
#92.
ブラジルでのoutbreak 2016年12月から流行中 2016年12月-2017年6月 診断確定例 779例(うち死亡262例) 2017年12月-2018年5月 診断確定例 1266例(うち死亡415例) ワクチン未接種の旅行者の発症あり サンパウロ市近郊での発症例あり WHO. Weekly Epidemiological Record, 10 August 2018.
#93.
-
#94.
感染経路:3つの伝播サイクル ジャングル サバンナ 都市部 ヒトが蚊への感染性を持つ(ウイルス血症の)期間: 発熱の少し前~発症5日以内
#95.
多くはジャングル・サバンナ型 ジャングル型 サルなどのヒト以外の霊長類と蚊で感染サイクル サル→蚊→(ジャングルに入った)ヒトで感染 サバンナ型(アフリカのみ) 蚊→ヒトまたはサル→蚊→ヒトまたはサルで感染 ジャングル周辺に居住するヒト 都市型 ヒト→蚊→ヒトで感染
#96.
症状 潜伏期間:3-6日 多くの場合、無症状(不顕性感染) インフルエンザ様の症状で発症 - 突然の発熱、頭痛、筋肉痛 - 吐き気、嘔吐、背部痛、倦怠感、など - 多くの場合、症状は3-4日で改善する
#97.
症状 15%が重症化する - いったん24時間以内解熱 - その後、再度悪化する - 出血・ショック・黄疸・臓器障害 - 7-10日以内に約半数が死亡する
#98.
診断・治療・予後 診断 - 曝露状況、ワクチン接種歴 - 抗体検査(IgMとIgG) - PCR(遺伝子検査):発症3-4日以内 特異的な治療法はない 重症化した場合の死亡率は20-50%
#99.
予防 ワクチン接種 防蚊対策 - DEET含有虫よけ剤 - 長袖・長ズボン - 蚊帳
#100.
公衆衛生上の取り組み 集団ワクチン接種 感染リスクの情報伝達 医療サービスの強化 媒介生物(蚊)の調査と制御 - 感染リスクのある地域の抽出に有用 - 水たまりなどの蚊の繁殖地を排除 - 殺虫剤での制御には限界がある WHO. Yellow fever. Fact sheet, 1 May 2018.
動物由来感染症:狂犬病とアフリカ睡眠病
#101.
黄熱ワクチン 皮下注射、1回接種 効果はほぼ100%(接種10日後から生涯効果あり) - 接種10日以内に80-100% - 接種30日以内に99% 1例のみワクチン接種者での発症報告あり - 1988年、スペインからの渡航者、生存 入国に際して予防接種証明書を要求する国がある - 黄熱の流行国 or 流行国の近隣の国 生後9か月以上から接種可能 妊婦・授乳中の接種は、禁忌ではない
#102.
黄熱ワクチン 2016年7月11日以降は、 1回接種で生涯有効となった 以下の場合は、再接種を検討 - 初回接種時に妊娠していた場合 - 初回接種後に造血幹細胞移植した場合 - HIV感染症(10年おき) ※CD4 <200 /mm3の場合は禁忌
#103.
Yellow Card International Certificate of Vaccination or Prophylaxis 略すると「ICVP」 日本語では黄熱予防接種証明書
#104.
Yellow Card
#105.
ジカ熱
#106.
ジカ熱 ジカウイルス(Zika virus)による感染症 ヤブ蚊によって媒介される感染症 ヤブ蚊は、デング熱・チクングニア熱・黄熱も媒介する(主に日中に活動する) 性交渉でも稀に感染することがある
#107.
歴史 1947年にウガンダのサルから分離 1952年に初めてウガンダとタンザニアでヒトから分離 1960-1980年代はアフリカ・アジア・アメリカ大陸で発生 2007年に最初のoutbreak(ミクロネシア連邦のヤップ島) 2013年にフランス領ポリネシアでoutbreak 2015年にブラジルなどの中南米でoutbreak その後アジア・アフリカなどに拡がった 2018年7月時点で、蚊の媒介によるジカウイルス感染症は、86か国で報告されている WHO. Fact sheet. 20 July 2018. http://www.who.int/en/news-room/fact-sheets/detail/zika-virus
#108.
ジカのリスクのある地域 アンゴラ ガーナ
#109.
デング熱の流行地域
#110.
チクングニア熱の流行地域
#111.
ネッタイシマカとヒトスジシマカの生息地
#112.
分布が一致 ジカ熱 デング熱 チクングニア熱 ヤブ蚊
#113.
感染経路
#114.
感染経路 感染した蚊に刺される(最多) 妊婦から胎児に感染する 性交渉 輸血、臓器移植、検査室での曝露 母乳での感染報告例はない
#115.
感染の伝播において感染者の症状の有無は関係ない
#116.
症状 症状は軽度またはないことが多い 成人の感染者の20-25%が症状出現 潜伏期間:2-14日 発熱、皮疹、頭痛、結膜炎、筋肉痛、関節痛、腹痛、下痢などの症状が2-7日持続する 自然に症状は改善する
#117.
合併症 妊婦が感染した場合 - 小頭症のリスクが上昇する(5.8%) 第1期:約10%、第2期:3.2%、第3期:4.4% - その他の先天性の異常も増加する →四肢の奇形、網膜異常、難聴 etc - 妊娠中にジカウイルスに感染した場合 5-15%の新生児になんらかの感染の合併症がみられる - 早産・流産も増加する 神経合併症 - ギランバレー症候群、末梢神経障害、脊髄炎と関連する WHO. Zika virus: Fact Sheet, 20 July 2018. N Eng J Med 2018;378:985-994
#118.
診断と治療 診断 - 核酸増幅法(尿:発症14日以内、血清:発症7日以内) - 抗体検査(ペア血清) - デング熱とチクングニア熱も検査する 治療 - 特異的治療なし、対症療法 - NSAIDsはデングを除外するまでは控える
#119.
ウイルスの検出 ジカウイルスのRNAは以下の検体で検出可能 - 血液 - 尿 - 精液 - 唾液 - 膣分泌液 - 脳脊髄液 - 羊水 - 母乳
#120.
ウイルス検出期間 血液:通常約2週間以内 - 発症から81日目で検出した報告がある 尿:通常約6週間以内 - 発症から91日目で検出した報告がある 精液:通常約3か月以内 - 発症から188日目で検出された報告がある Zika virus infection: An overview. UpToDate 2018
#121.
血清中Zika RNA N Engl J Med 2018;379:1234-43 RNA消失の中央値:15日 95%で消失:41日 妊婦で、最長で発症後83日までRNAが検出された
#122.
尿中Zika RNA RNA消失の中央値:11日 95%で消失:34日 N Engl J Med 2018;379:1234-43
#123.
精液中Zika RNA RNA消失の中央値:42日 95%で消失:120日 発症から90日時点:11%の患者でRNAが検出 最長191日目でRNAが陽性 N Engl J Med 2018;379:1234-43
#124.
ウイルス排泄と感染性 精液中のウイルスは、いつまで感染性があるかはっきりしていない(あくまで検査は、ウイルスRNAを検出しているだけ) 感染源となった患者の発症から41日目に、性交渉による感染が起こった報告がある 感染性のあるウイルスが、発症から69日目の精液から分離された報告がある
#125.
予防 防蚊対策 - DEET含有虫よけ剤(イカリジンもOK) - 長袖・長ズボン - 蚊帳、エアコンの使用 - 帰国後3週間はDEETを使用(症状関係なし) 性交渉を控える (またはコンドームを使用:膣・肛門・口腔) 妊婦は、ジカのリスクのある地域を旅行すべきでない 献血は、帰国後(発症後)4週間はだめ 授乳はOK
#126.
性交渉を控える期間 ※MMWR Morb Mortal Wkly Rep 2018;67:868-871
#127.
デング熱・チクングニア熱
#128.
要点 ヤブカによって媒介される感染症 - 主にネッタイシマカだが、ヒトスジシマカでも伝播しうる 潜伏期間:2-14日(典型的には3-7日) 流行地域:東南アジア・インド・中南米・アフリカ インフルエンザのような症状で発症 デング熱 - 重症例:腹痛や嘔吐などの腹部症状、出血傾向、血圧低下 - 2回目以降の感染で、重症化しうる
#129.
症状の比較
#130.
診断・治療 診断 - 血液PCRと抗体検査(IgGとIgM) - 血清抗原(デング) 治療:対症療法 - デングでは、NSAIDsを使用してはいけない 自然軽快する
飛沫感染する疾患:髄膜炎菌と麻疹
#131.
ハエ媒介感染症
#132.
アフリカ睡眠病 アフリカトリパノソーマ症
#133.
アフリカトリパノソーマ症 Trypanosoma bruceiによる原虫感染症 サハラ以南アフリカの36か国でみられる 感染制御によって、減少傾向である 2つの型 - ガンビア・トリパノソーマ(98%以上) 西・中央アフリカ24か国 - ローデシア・トリパノソーマ アフリカ東部・南部13か国 - どちらも流行しているのはウガンダのみ
#134.
感染経路 感染したツェツェバエに刺されることで感染する - ツェツェバエは農村部、日中に活動 母子感染(母→胎児) 輸血 針刺し 性交渉 https://www.cdc.gov/parasites/sleepingsickness/epi.html
#135.
生活環 ガンビア型:ハエ→ヒト→ハエ
#136.
疫学 2015年 - 新規報告数 2804人 - 報告数は減少傾向 - ただしほとんどの症例は報告されていない - 実際の推定患者数 20,000人程度 - 危険に晒されている人 6,500万人 WHO Fact Sheet, 16 Feb 2018. http://www.who.int/news-room/fact-sheets/detail/trypanosomiasis-human-african-(sleeping-sickness)
#137.
ガンビア型 ローデシア型 報告数は年々減少している PLoS Negl Trop Dis 11(5):e0005585 ほとんどがコンゴ民主共和国 アンゴラは2014年時点で36例 マラウィは約30例
#138.
2010-2014年のデータ PLoS Negl Trop Dis 11(5):e0005585 アフリカ・トリパノソーマの発生数
#139.
疫学 ガンビア・トリパノソーマ - Trypanosoma brucei gambiense - 西アフリカ24か国 - ほとんどがコンゴ民主共和国 過去10年に報告された患者の70%以上を占める - 中央アフリカ共和国 - アンゴラ、南スーダン、コンゴ共和国 - チャド、ウガンダ北部
#140.
疫学 ローデシア・トリパノソーマ - Trypanosoma brucei rhodesiense - アフリカ東部と南部の13か国 - タンザニア、ウガンダ、マラウィ ザンビア、ジンバブエ など - ウガンダでは2つの型が見られるが、流行地域はかぶっていない WHO Fact Sheet, 16 Feb 2018. http://www.who.int/news-room/fact-sheets/detail/trypanosomiasis-human-african-(sleeping-sickness)
#141.
症状 ガンビア・トリパノソーマ - 月または年単位で症状が出現 - 第1期(血液リンパ期): 間欠的発熱、頭痛、倦怠感、筋肉痛、顔面浮腫 関節痛、かゆみ、リンパ節腫脹、体重減少 など - 第2期(中枢神経期): 中枢神経症状(日中の傾眠、睡眠サイクルの異常、強い頭痛、気分障害、異常行動、局所神経症状など)は、感染の数か月から数年後に出現
#142.
症状 ローデシア・トリパノソーマ - 感染から1-3週間で症状が出現(急性) - 高熱、刺咬部位の下疳、皮疹、頭痛、筋肉痛など - 1か月以内に中枢神経症状(睡眠サイクルの異常・意識障害など)が起こる(第2期) - 心筋炎を起こすことがある
#143.
診断 寄生虫の鏡検 - 血液 - リンパ節吸引液 - 下疳中の体液 - 脳脊髄液 https://www.cdc.gov/parasites/sleepingsickness/diagnosis.html 末梢血スメアのギムザ染色
#144.
治療 抗トリパノソーマ薬 ガンビア・トリパノソーマ - 第1期:ペンタミジン - 第2期:エフロルニチン±ニフルチモックス ローデシア・トリパノソーマ - 第1期:スラミン - 第2期:メラルソプロール
#145.
予防 ハエに刺されないようにする 長袖・長ズボン・中間色の厚手の服 - 薄い衣類だと、ハエによる刺咬で貫通する DEET含有虫よけ剤 茂みを避ける(ハエが多い) ツェツェバエは明るい色や暗い色に引きつけられるため、周囲の環境と区別のつきにくい色彩の衣服がよい ワクチンと予防内服の効果は示されていない
#146.
予防(社会全体) Vector control - 媒介昆虫を減らす試み - 殺虫剤の空中散布、不妊虫放飼 ハエトラップ、殺虫剤含有スクリーン、など サーベイランス - ヒトがT. b. gambienseの主な宿主である - スクリーニング→早期診断・早期治療 - ヒト-ハエ-ヒトの伝播を減少させる
#147.
ダニ媒介感染症
#148.
ペスト
#149.
細菌と感染経路 Yersinia pestisによる感染症 感染経路 - 感染したノミの咬傷 野ネズミなどの小さな哺乳類に感染 ノミを通じてヒトに感染する - 感染したヒトまたは動物への接触 - 飛沫感染(稀→肺ペストの患者の場合)
#150.
CDC. Plague. Fact sheet. https://www.cdc.gov/plague/resources/235098_Plaguefactsheet_508.pdf
淡水感染症:住血吸虫とレプトスピラ
#151.
疫学 2010-2015年:世界で3248例(死亡者584名) 日本では、1926年以降報告なし ほとんどがサハラ以南アフリカ - 2000年以降、95%以上がアフリカ 3つの流行地域 - マダガスカル - コンゴ民主共和国 - ペルー
#152.
ペスト発生地域 2010-2015年
#153.
ペスト感染リスクのある地域 WHO. Plague Fact Sheet. http://www.who.int/csr/disease/plague/Plague-map-2016.pdf
#154.
マダガスカル 2017年8-11月 - 都市部で肺ペストがアウトブレイク - 11月27日に終息宣言 ほぼ毎年9月から4月にかけて流行 多くは、地方(農村部)で発生する
#155.
2017年8月1日から11月24日 ・ペスト患者:2384人 ・死亡者:207名(9%) ・肺ペスト:1828人(77%) ・腺ペスト:347人(15%) http://apps.who.int/iris/bitstream/handle/10665/259514/Ex-PlagueMadagascar27112017.pdf;jsessionid=C761BB42C0DC4709F2A55968E37E286E?sequence=1
#156.
分類と症状 腺ペスト(Bubonic plague) もっとも多いタイプ(80-90%)、潜伏期間は1-7日 急な高熱と非特異的症状(悪寒、虚脱、頭痛が起こる 所属リンパ節(鼠径・腋窩・頸部)の有痛性腫脹 敗血症型ペスト(Septicemic plague) 急激な発熱、ショック症状、多臓器不全 肺ペスト(Pneumonic plague) 菌血症からの進展で起きる病型 両側性、びまん性肺胞陰影を呈する
#157.
診断 早期診断と早期治療が重要 - 治療しない場合の死亡率 腺ペスト:50-60% 肺ペスト・敗血症型ペスト:100% 診断 - 膿・血液・痰からY. pestisを検出 - PCR、抗体検査
#158.
治療 治療 - 抗菌薬の効果は高い - ストレプトマイシンまたはゲンタマイシン - 代替薬:レボフロキサシン、テトラサイクリン 予後(治療した場合の死亡率) - 腺ペスト:10-20% - 肺ペスト:50%
#159.
予防 ノミ咬傷予防 - ノミへの曝露する行動を減らす - 肌の露出を避ける(長袖、長ズボン) - DEET含有虫よけ剤を使用する 患者や感染した(可能性のある)動物、その体液・排泄物を触らない 曝露後予防:ドキシサイクリン内服
#160.
流行の制御 感染源の発見と感染源の封じ込め 小動物の死体が大量に存在する地域などを調査して、感染源と特定する まずノミを駆除して、その後げっ歯類を駆除 医療従事者の保護 感染の予防と制御について周知・訓練する 患者に対面する場合、個人防護具を装着 患者と接触した場合は、抗菌薬予防内服を行う 適切な治療の施行 適切な抗菌薬の投与 地域への抗菌薬供給量が十分であるか確認する WHO Oct 31, 2017. http://www.who.int/en/news-room/fact-sheets/detail/plague
#161.
流行の制御 肺ペスト患者の隔離 飛沫感染対策 サーベイランス(調査活動) 肺ペスト患者との濃厚接触者を確認・モニターする 肺ペスト患者との接触者は、7日間の抗菌薬予防内服を行う 腺ペスト患者の家族に、抗菌薬予防内服を施行する 適切な方法で検体を採取し検査機関へ搬送する 消毒 流水と石鹸、または、アルコール製剤で手洗いを行う 安全で確実な埋葬の実施 WHO Oct 31, 2017. http://www.who.int/en/news-room/fact-sheets/detail/plague
#162.
水・食事で感染する疾患
#163.
水・食事で感染する疾患 コレラ A型肝炎 腸チフス ポリオ アメーバ腸炎
#164.
コレラ
#165.
コレラ Vibrio choleraeによる急性感染性腸炎 以下の2つの血清型による - O1:世界の流行株のほとんどを占める - O139:アジアに限局 多くの場合は不顕性感染または軽症 稀に重症化
#166.
疫学 世界約50か国、アフリカ、東南アジア、南アジア、カリブ海諸国で流行している 毎年130-400万人の患者が発生し、21,000-143,000人が死亡していると推定されている 2016年は、38か国から13万人以上の患者が報告された(うち死亡者 2420人:1.8%)。コンゴ民主共和国、ハイチ、ソマリア、タンザニア、イエメンで80%を占める。 ほとんどの症例は報告されていない http://www.who.int/en/news-room/fact-sheets/detail/cholera Yellow Book 2018. Cholera.
#167.
Mandell, Douglas, and Bennett's Principles and Practice of Infectious Diseases, 8th Edition, Chapter 216. 罹患率
#168.
感染経路 コレラ菌に汚染された水または食事(特に海産物)を摂取することにより感染 ヒト-ヒト感染は基本的に起こらない コレラの流行は、水の安全性と下水道整備が不十分であることと深く関連 スラム街、難民キャンプは高リスク
#169.
症状 潜伏期間:12時間から5日(通常1-2日) 典型的には、下痢・嘔吐が2-3日持続する 腹痛や発熱は少ない 症状がなくても、1-10日間は便中にコレラ菌を排菌する
#170.
重症例 重症例(約10%)では - 大量の米のとぎ汁様の下痢 - 1時間に1L下痢することもある - 脱水と電解質異常が問題となる - 重度の下痢は、最初の2-3日 - 4-6日で下痢は止まる
#171.
診断と治療 診断 - 便培養、血清型の確認 治療 - 補液(経口 or 点滴) - 5歳未満の子供:亜鉛を補充 - 抗菌薬(ドキシサイクリン 300mg 単回) 小児と妊婦はアジスロマイシン 1g 単回 - 適切な治療を行えば、死亡率は1%未満
#172.
経口補水療法 oral rehydration solution(ORS) Na:ブドウ糖=1:1が最適 Na:60-90 mEq/L K:15-25 mEq/L Cl:50-80 mEq/L クエン酸:8-12 mmo//L ブドウ糖:20g/L以下
#173.
OS-1 Na+:50 mEq/L K+:20 mEq/L Cl-:50 mEq/L ブドウ糖:1.8%
#174.
家でつくる場合 沸騰させた水1L 食塩3g(小さじ0.5杯)→Na 51mEq 砂糖18g(小さじ6杯) レモン汁を適宜(Kとクエン酸) を混ぜる
#175.
予防 安全な水と食事のみ摂取する 頻回の手洗い ワクチン接種 予防的抗菌薬の効果はない
#176.
予防:水と食事 飲料水 - 1分以上煮沸または塩素処理 - ミネラルウォーターを使用 野菜と魚は十分に加熱調理する コレラが流行している国では、生水、氷(氷と接触のあるカットフルーツなども含む)、生の魚介類を避ける プールの水(の飲水)から感染することもある 飲み水の安全と衛生環境の改善が重要
#177.
予防:ワクチン 経口不活化コレラワクチン - 日本では認可されていない - 輸入ワクチンとして使用 - 2種類使用可能 - 適応:コレラ流行地域への旅行者 品川イーストクリニックhttp://japantravelclinic.com/vaccine/cholera.html
#178.
Dukocal® 不活化全細胞遺伝子組み換えBサブユニット経口ワクチン O1型のみをカバー 腸管毒素原性大腸菌感染症にもある程度予防効果 2回内服(0, 1-6w)が基本、各doseは1-6週間間隔 効果:最初の半年の予防効果は85-90% 50-60%は2年間効果が持続した 2歳以上に投与可能、2-5歳は3回目の投与が必要 前後1時間は絶食(酸分泌で効果が弱まる) 2年毎にboosterが必要
#179.
Shanchol® 2価全細胞不活化経口ワクチン O1型とO139型をカバー 2回内服(0, 2w) 効果:53-67%の予防効果 5年間持続する 1回投与でも短期間の予防効果がある 1歳以上に投与可能 Lancet 2009;374(9702):1694-702、N Engl J Med. 2016;374(18):1723-32 Lancet Infect Dis. 2013;13(12):1050-6
#180.
公衆衛生における対策 サーベイランス(調査活動) 水の安全と衛生環境の改善 - 経済発展 - 安全な飲料水と十分な衛生設備 教育 - 石鹸による手洗い、安全な調理・食品の保管 - 子供の糞便の清潔な処理 適切な治療 - 糞便からコレラ菌が排泄される量と期間を減らす 経口コレラワクチン - リスクの高い地域・流行している地域での集団ワクチン接種 WHO. Cholera, fact sheet, 1 Feb 2018.
感染症予防のための公衆衛生対策と教育
#181.
A型肝炎
#182.
A型肝炎 A型肝炎ウイルスに感染して発症する アフリカとアジアで特に流行している 安全な水の不足や、不十分な衛生環境、不潔な手などへの衛生意識が、感染リスクと関連している 慢性感染を起こすことはない 稀に劇症肝炎となり死亡することがある 全体の死亡率は0.3%、50歳以上だと1.8%
#183.
感染経路 A型肝炎ウイルス(感染者の便)に汚染された食べ物・水を摂取 感染者への濃厚な接触(糞口感染) - 性行為(特にoral sex、anal sex)・家族内発症 感染者は、症状出現の1-2週間前から糞便中にウイルスを排泄する(症状が出現してからはウイルス排泄は減少する)
#184.
疫学
#185.
症状 潜伏期間:15-50日(平均28日) 症状は、軽症から重症まで幅がある 発熱、倦怠感、食欲不振、下痢、悪心、腹部の不快感、褐色尿、黄疸 年齢が高いほど、症状は強くなる 6歳未満の場合、70%は無症状
#186.
感染のリスク 不十分な衛生環境 安全な水の不足 注射薬物使用者 感染した人との同居生活 急性A型肝炎に感染している人の性的パートナー 予防接種を受けずに、ウイルスの流行地域に渡航する人
#187.
診断・治療 診断 - HAV IgM(抗体)の検出 - 症状出現の2週間前から検出可能 治療 - 対症療法
#188.
予防 ワクチン接種 免疫グロブリン(1歳未満) - 1-2か月間効果がある 食事と水に注意する - 十分に加熱した飲食物を摂取(85℃ 1分以上) - 冷凍は効果ない 手洗い
#189.
A型肝炎ワクチン エイムゲン®(国産ワクチン) - 年齢制限はないが、基本的に1歳以上 - 3回接種、筋注、0, 2-4w, 6M - 2回接種で抗体価は上昇するが、長期免疫のため3回目が必要 Havrix®(輸入ワクチン) - 1歳以上 - 2回接種、筋注 - 0, 6-12M - 初回接種の2週間後に90%で抗体価上昇 - 接種者の95%以上が、20年以上の効果持続
#190.
A型肝炎ワクチンの適応 ウイルスの流行地域への渡航者 娯楽での薬物使用者 男性同性愛者 慢性肝疾患(HBVやHCV) - 罹患した場合に重症化するため HAVを扱う研究者
#191.
公衆衛生対策 安全な飲料水の供給 安全な食料品の供給 衛生環境の改善 A型肝炎ワクチン接種
#192.
腸チフス
#193.
腸チフス・パラチフス 腸チフス - Salmonella enterica serotype Typhi パラチフス - Salmonella enterica serotype Paratyphi A - Salmonella enterica serotype Paratyphi B - Salmonella enterica serotype Paratyphi C
#194.
腸チフス 腸チフスは、腸チフス菌を原因とする感染症 腸チフスとパラチフスを合わせて、Enteric feverと呼ぶ 推定で1,110万から2,000万人が腸チフスに罹患、毎年128,000-161,000人が死亡 パラチフスは、年間500万人程度と推定 耐性菌が増加傾向で、問題となっている WHO. Typhoid. Fact Sheet. 1/2018. CDC. Yellow Book.
#195.
疫学 Bulletin of the World health Organization 2004;82:346-353
#196.
疫学 南アジア 東南アジア アフリカ(特にサハラ以南) 中南米 西太平洋地域 の発展途上地域で流行している
#197.
感染経路 感染したヒトの便に汚染された水・食べ物を摂取することにより感染する - 罹患者またはキャリアの汚染された手・糞便 - 不十分な上下水道設備 ヒトにしか感染症を起こさない 安全な水の利用環境が不十分で、衛生設備が整っていない地域でリスクが高い
#198.
症状 潜伏期間:6-30日(平均7-14日) 遷延する発熱、疲労感、頭痛、吐き気、腹痛、下痢、便秘で発症する。一過性に体幹の皮疹が出現することがある。 咳や関節痛・筋肉痛が見られることもある 重症化すると、発症から2-3週間後に消化管出血や消化管穿孔を起こすことがある
#199.
診断と治療 診断 - 血液培養 感度40-80% - 骨髄培養 感度90%以上 - 便培養 感度30-40% 治療 - 抗菌薬の耐性化が進んでいる - 特に南アジア・東南アジアのキノロン系耐性 - セフトリアキソン、アジスロマイシンを使用 - 適切に治療すれば、死亡率は1%未満
#200.
予防 ワクチン接種 食べ物・水に注意 - 十分に加熱した飲食物を摂取する - 氷・生乳・生乳から作られた食品に特に注意 - フレッシュジュースにも注意(搾った手の汚染のrisk) - 生野菜や果物は、丁寧に洗い、皮を剥いて食べる - 手をしっかり洗う(特に食事前)
#201.
腸チフスワクチン 腸チフスの予防効果は50-80% パラチフスは予防効果はない 適応 - 腸チフスのリスクが高い地域への旅行者 2種類存在する - 注射用不活化ワクチン - 経口弱毒生ワクチン インドでのみ使用可能な結合型ワクチンもある
#202.
注射用不活化ワクチン Vi多糖体腸チフスワクチン 1回接種、筋注 渡航2週間以上前に接種 2歳以上で接種可能 2年おきに追加接種
#203.
経口弱毒生ワクチン Ty21a株経口腸チフスワクチン 3-4回内服(1日おきに内服)、渡航1週間前に完了 冷蔵保存 熱くない(37℃以下)飲み物で摂取する 空腹時内服(食前1時間、食後2時間) 抗菌薬投与と72時間以上の間隔をあける 6歳以上で接種可能、妊婦には投与しない 効果は3-7年(CDC:5年ごとの接種を推奨)
#204.
公衆衛生における対策 安全な水と適切な衛生設備の利用環境 衛生への教育 食品の取り扱い業者の間での衛生維持 腸チフスワクチンの接種 WHO. Typhoid. Fact Sheet. 1/2018.
#205.
ポリオ
#206.
ポリオ ポリオウイルスによる感染症 5歳未満の小児でリスクが高い 2017年は22例が報告された
#207.
疫学 流行しているのは以下の3か国のみ - パキスタン - アフガニスタン - ナイジェリア その周辺の国で輸入患者の発生がある
#208.
感染経路 糞口感染 ポリオに感染した人の便中にポリオウイルスが排出され、汚染された手・水・食物によって感染する
#209.
症状 感染しても90-95%は症状がない 潜伏期間:3-35日(7-14日) 発熱、頭痛、咽頭痛、吐き気、嘔吐 下肢などの麻痺、呼吸筋麻痺 200人に1人に不可逆的な麻痺がおこる 麻痺を起こした患者の5-10%は死亡
#210.
診断・治療 診断 - 便中のポリオウイルスの分離 - 脳脊髄液中のポリオウイルスPCR 治療 - 対症療法
#211.
予防 ワクチン接種 - IPV(inactivated polio vaccine) 不活化ワクチン 現在日本で流通しているもの(2012年から) - OPV(live oral polio vaccine) 経口ポリオ生ワクチン もともと日本で定期接種されていたもの 食事の前の十分な手洗い
#212.
ポリオワクチン IPV - 3回、筋注、0, 1M, 7M - 小児期に完了している場合、流行地への渡航前に1回追加接種(booster) OPV - 日本の定期接種では、2回接種であった - 現在OPV使用している諸外国では3回接種が基本 - 200-300万人に1人ワクチン関連麻痺性ポリオ - 1975年-1977年生まれの人は、ポリオに対する免疫が低いとされる 渡航外来では、今まで使用したワクチンの種類・接種回数・接種時期から、必要接種回数を決める
#213.
水・食べ物での注意点
#214.
食べ物で注意すること 5つのkey points 食事前にしっかりと手を洗う 食べものはしっかりと火を通す 安全な水と食べものを選ぶ - アイスクリーム、飲料水、氷、ミルクに注意 - 果物は皮をむいて食べる - 緑色の野菜は、生では食べない - 水は、ミネラルウォーター、または、煮沸 生ものと調理済みのものを接触させない 食事は安全な温度でおいておく - 調理した食事は、長時間室温に放置しない(5-60℃が危険) WHO. A Guide on Safe Food For Travelersから引用
#215.
スタンバイ治療 旅行者下痢症の罹患リスクが高い地域 カンピロバクター、チフス、サルモネラ スタンバイ治療を考慮する 下痢が始まったときに、自己治療する アジスロマイシン(ジスロマック®) 500mg 1日1回 3日間
#216.
動物との接触で感染する疾患
#217.
動物との接触で感染する疾患 狂犬病 H5N1 鳥インフルエンザ 破傷風
#218.
狂犬病
#219.
狂犬病 リッサウイルス属 狂犬病ウイルス 感染した動物の唾液を通じて、咬傷やひっかき傷から感染する 発症したら死亡率はほぼ100% ワクチン接種(ヒト・犬)によって100%予防可能な疾患である
#220.
疫学 150以上の国と地域で発生 99%以上は犬からの感染 死亡者は59,000人以上と推定されている →9分に1人死亡していることになる 死亡者の95%はアジアとアフリカ - アジア35,000人、アフリカ21,500人 - インドが、アジアの約60%を占める 死亡者の40%は15歳未満
#221.
犬とヒトの狂犬病の流行状況 犬流行、ヒトあり 犬流行、ヒトなし 犬わずか 犬ほぼなし
#222.
狂犬病のリスク
#223.
感染経路 全世界でみると99%以上は犬からの感染 アジア・アフリカ:犬が多い アメリカ大陸:コウモリが最多 - キツネ、アライグマ、スカンク、ジャッカル、マングース、その他の哺乳類は稀
#224.
症状 潜伏期間:一般的に1-3か月 1年以上のこともある 初期症状:発熱、創部の痛み・感覚異常 その後進行して、中枢神経症状が出現 狂躁型:活動亢進、興奮、恐水症、数日で死亡に至る 麻痺型:創部から麻痺が出現し、全身に拡がる、意識障害もゆっくり進行し、死に至る
#225.
診断・治療 診断 - 病歴(曝露歴、ワクチン接種歴、経過) - 抗体検査、PCRなど 治療 - 症状緩和治療
#226.
予防 曝露前予防 曝露後予防
#227.
ワクチンによる曝露前予防 Verorab®(精製ベロ細胞ワクチン:PVRV) Rabipur®(精製ニワトリ胚細胞ワクチン:PCECV) - 3回接種、筋注、0, 7d, 21 or 28d - 筋注部位は、三角筋 or 大腿四頭筋(小児) - 2回接種(0, 7d)でもよいかも 国産狂犬病ワクチン(PCECV) - 3回接種、皮下注、0, 1M, 6-12M WHO. Weekly epidemiological record 2018;93:201–220.
#228.
曝露後予防 できるだけ早期に創部の洗浄 - 流水と石鹸、ポビドンヨードの使用 - 15分以上洗浄する 狂犬病ワクチン 狂犬病免疫グロブリン(必要時) 破傷風トキソイドの必要性も検討 WHO. Rabies: fact sheet, 13 September 2018.
#229.
曝露後予防の対象 狂犬病のリスクのある国 犬、コウモリ、その他すべての哺乳類による咬傷、ひっかき傷
#230.
曝露後予防
#231.
曝露後のワクチン接種 曝露前ワクチン接種歴がある場合 - 曝露後は、day 0, 3の2回接種 - 国産ワクチンでのdataはない - 狂犬病免疫グロブリンは不要
#232.
曝露後のワクチン接種 曝露前ワクチン接種がない場合 輸入ワクチンの場合 - 5回接種:day 0、3、7、14、28 ※CDCは、免疫不全者のみday 28を推奨 - 4回接種:day 0、3、7、14-28 国産ワクチンの場合 - 6回接種、皮下注 - day 0、3、7、14、30、90 WHO. Weekly epidemiological record 2018;93:201–220.
#233.
免疫グロブリン 日本では入手困難 初回ワクチン接種から7日以内に投与 なるべく早く投与
#234.
曝露源の生存確認 曝露源がイヌ・ネコ・フェレットの場合、それらが曝露後10日間生存している場合、曝露後予防を中止できる
#235.
公衆衛生における対策 狂犬病のモニタリングとサーベイランス 犬へのワクチン接種(70%が目安) 教育(特に子供) - 狂犬病についての知識 - 噛みつかれないようにする方法 - 咬まれた場合の対応方法 曝露前ワクチン接種 曝露後予防へのアクセスの向上
#236.
性交渉で感染する疾患
#237.
海外渡航と性交渉 海外渡航者の約20%が渡航関連の行きずりの性交渉(casual sex)を経験している そのうち約50%がコンドームを使用しなかった Int J Infect Dis. 2010;14(10):e842-51
#238.
日本人のdataも含まれている ハワイでのdataでは、日本人渡航者(旅行者、学生、パートタイム労働者)の17.7%がcasual sex(風俗店従業者との性交渉は含まない)を経験している 女性 18.9%、男性 16.2% casual sexで常にコンドームを使用していたのは、約25%程度 AIDS Educ Prev 2007;19(1):68-81
#239.
casual sexのリスク因子 若年 男性(男性24.8%、女性19.5%) 独身 単身での旅行 or 友人との旅行 複数の性的パートナー歴 性感染症の既往 長期滞在者 男性同性愛者 Int J Infect Dis. 2010;14(10):e842-51
#240.
性交渉で感染する疾患 B型肝炎 HIV 梅毒 淋菌 クラミジア 膣トリコモナス 単純ヘルペス アメーバ腸炎 A型肝炎
#241.
B型肝炎の罹患リスクが中等度以上の地域
#242.
A型肝炎の罹患リスクが中等度以上の地域
#243.
性交渉で感染する熱帯病 エボラウイルス病 ジカ熱
#244.
性交渉しない 性交渉する場合は、コンドームを使用 - vaginal, oral, anal sexすべてを含む A型肝炎ワクチン B型肝炎ワクチン 性感染症の予防 https://wwwnc.cdc.gov/travel/page/std 日本製がよいでしょう
#245.
B型肝炎ワクチン 適応 - HBs抗原陽性者が2%以上の地域への旅行者 - 現在、小児は全員接種(universal vaccine) ビームゲン® or ヘプタバックス® - 3回接種、筋注 - スケジュール:0, 1M, 6M
#246.
High ≧8% High intermediate 5-7% Low inter mediate 2-4% low <2% no data https://wwwnc.cdc.gov/travel/yellowbook/2018/infectious-diseases-related-to-travel/hepatitis-b
#247.
A型肝炎・B型肝炎混合ワクチン Twinrix®:輸入ワクチン - 3回接種、1.0ml、筋注 - 18歳以上で使用可能(米国) - スケジュール:0, 1M, 6M 加速法(Accelerated schedule) - 0, 1w, 3w, 12M - 初回接種から1か月で65%、7週間で76%で抗体価が上昇 - 渡航まで1か月しかない場合は、この方法を選択することがある
#248.
飛沫・空気感染する疾患
#249.
飛沫・空気感染する疾患 髄膜炎菌 結核(空気感染) 肺ペスト 麻疹(空気感染) 風疹
#250.
髄膜炎菌感染症
#251.
髄膜炎菌感染症 髄膜炎菌は、髄膜炎や菌血症を起こす ⾎清型によって12種類に分類 6種類(A、B、C、W、X、Y)が流⾏ サハラ以南アフリカ26か国が最大の流行地域(髄膜炎ベルト) 乾季(12月-6月)に特に流行する 適切に行われたサーベイランスデータはないが、髄膜炎ベルト地帯から、約3万人の報告がある
#252.
感染経路 ヒトにのみ感染する 他の動物を宿主としない 飛沫感染 - 発病者または保菌者から感染する - 呼吸器からの飛沫や咽頭分泌物 - 咳、くしゃみ、キスなどの接触 保菌者が1-10%存在するとされる
#253.
疫学 サハラ以南アフリカで流行 A型結合型ワクチンによりA型は減少 W型、X型、C型は依然として流行 サウジアラビアのメッカ大巡礼(ハジ) 日本での発症は、年間約40例程度
#254.
-
#255.
-
#256.
症状 潜伏期間:4日(1-10日) 発症者の50%以上が髄膜炎を呈する 高熱、光過敏症、錯乱、頭痛、嘔吐 出血性の皮疹、循環不全、ショック 死亡率10-15%
#257.
診断・治療 診断 - 血液培養、髄液培養 治療 - 抗菌薬(セフトリアキソン)
#258.
予防 ワクチン接種 :結合型ワクチン(ACY-W135) メナクトラ® 日本で接種可能、1回、筋注 効果は5年以上(5年に1回booster) 効果:80-85%
#259.
予防 飛沫感染対策 - 治療開始24時間まで必要 化学予防 - 抗菌薬の予防投与 - 濃厚接触者に行う - なるべく早期(24時間以内が望ましい) シプロフロキサシン内服 500mg 1回 セフトリアキソン筋注 250mg 1回
#260.
麻疹
#261.
麻疹 麻疹ウイルスによる感染症 感染力が非常に強い(曝露したら90%で感染) ヒトにのみ感染を起こす 2016年(WHO発表)の疫学 - 罹患者数は、700万人と推定 - 世界で89,780人が死亡(大半が5歳未満) (年間死亡者数が初めて10万人以下となった) - 2000年→2016年で死亡者は84%減少 WHO. Measles: Fact sheet, 20 Sep 2018. CDC measles, Yellow Book.
#262.
感染経路 感染経路 - 空気感染:2時間程度 - 飛沫感染:咳、くしゃみ - 接触感染:気道分泌液への接触 など 発疹が出現する4-5⽇前から発疹が消退した4⽇後まで、感染⼒がある
#263.
疫学 多くは発展途上国で発生している - アフリカ - アジア - 旧ソ連 など 先進国でも一過性の流行はよく起こっている(罹患者の多くはワクチン接種歴がない)
#264.
Incidence 2017-08 - 2018-07 Number of cases / population 100,000
#265.
症状 潜伏期間:10-12日(7-21日) カタル期(2-4日) - 発熱、倦怠感、咳、鼻汁、咽頭痛、結膜炎 - コプリック斑 発疹期(4-7日) - 頭頸部から出現し、全身に拡がる 回復期 肺炎、脳炎を合併することがあり、死亡原因となる 高齢者、5歳未満の小児、妊婦、免疫不全者、低栄養で重症化しやすい
#266.
診断・治療 診断 - PCR(血液、尿、咽頭ぬぐい液) - 抗体(ペア血清) 治療 - 対症療法 - 小児:ビタミンA
#267.
予防 ワクチン接種 - 生ワクチン、皮下注、2回 - 4週間以上の間隔で接種 - 日本の添付文書:3か月以上の間隔で接種 - 定期接種(日本):1歳、年長 効果:99% 曝露後予防 - 72時間以内にワクチン接種 - 72時間以上、6日未満:免疫グロブリン
#268.
世界の約85%の1歳の小児が 1回目のワクチン接種を受けた 罹患者数は著減
#269.
淡水との接触で感染する疾患
#270.
淡水との接触で感染する疾患 住血吸虫 レプトスピラ
#271.
住血吸虫
#272.
住血吸虫症 Schistosoma属による感染症 寄生虫>蠕虫>吸虫 皮膚から感染する唯一の吸虫 世界中の2億人以上が感染している 年間20万人が死亡している 世界の住血吸虫症の90%はアフリカ大陸
#273.
種類 Schistosoma haematobium ビルハルツ住血吸虫:泌尿生殖器に寄生 Schistosoma mansoni マンソン住血吸虫:腸管に寄生 Schistosoma japonicum 日本住血吸虫:腸管に寄生 Schistosoma mekongi メコン住血吸虫:腸管に寄生 Schistosoma intercalatum インターカラーツム住血吸虫:腸管に寄生
#274.
分布 ビルハルツ住血吸虫 アフリカ、中東、トルコ、コルシカ マンソン住血吸虫 アフリカ、中東、南米、カリブ諸島 日本住血吸虫 中国(長江流域)、フィリピン インドネシア
#275.
アフリカは、 ・腸管-肝臓病変(S. mansoni) ・生殖泌尿器病変(S. haematobium) を形成する住血吸虫がどちらも流行 CDC. Yellow Book. 2018.
#276.
-
#277.
アフリカ旅行者の感染地域 バンフォラ(ブルキナファソ) ドゴン属の地域(マリ) マラウィ湖 タンガニーカ湖(タンザニア) ビクトリア湖 オモ川(エチオピア) ザンベジ川 ナイル川 https://wwwnc.cdc.gov/travel/yellowbook/2018/infectious-diseases-related-to-travel/schistosomiasis#5262
#278.
感染経路 住血吸虫に感染した巻貝が存在する淡水に皮膚が曝露した場合に、巻貝から放出されたセルカリア(寄生虫の成長ステージの一種)が、ヒトの皮膚を貫通して体内に侵入する 巻貝から放出された住血吸虫は48時間まで生存可能 汚染された淡水中を泳いでいる時、水浴びしている時、などに感染する(現地住民は、農業や漁業の作業中などに感染) 海水曝露では感染することはない
#279.
2日以内に死亡、感染性は放出後最初の数時間が高い 巻貝 皮膚から侵入 ヒトの体内で成長 尿・便から虫卵が排泄される
#280.
症状:急性感染症 通常無症状(寄生虫の侵入は気づかれないことがほとんど) 寄生虫(セルカリア)が侵入した部分に痒みを伴う皮膚炎(swimmer’s itch)が起こることがある(通常淡水曝露後数時間から数日以内) - 初感染では起こらない - 2回目以降の感染の場合で起こりうる
#281.
症状:急性感染症 片山熱 - 潜伏期間:3-8週間後 - 免疫のない旅行者で起こりやすい - 急性の発熱、寒気、筋肉痛、関節痛 - 咳、下痢、腹痛、血管浮腫 - 通常数日以内 - 長くとも数週間以内に自然軽快
#282.
症状:慢性感染症 腸管・肝臓に寄生する住血吸虫症 - マンソン住血吸虫や日本住血吸虫 腸管 - 下痢、血便、便秘、腹痛 - 進行すると、腸管が狭窄することもある 肝臓 - 肝臓腫大、脾腫、肝線維化、肝硬変 - 門脈圧亢進症→食道静脈瘤を形成
#283.
症状:慢性感染症 泌尿生殖器に寄生する住血吸虫症 - ビルハルツ住血吸虫 泌尿器 - 排尿時痛、血尿、頻尿 - 慢性膀胱炎、水腎症 - 膀胱癌(扁平上皮癌)のリスクが上昇 生殖器 - 生殖器病変、性器出血、外陰部結節 - 不妊
#284.
症状:慢性感染症 中枢神経病変 - 脊髄、脳の病変部位によって様々な症状 - サハラ以南アフリカにおける脊髄病変の原因の1-4%を占める 肺病変 - 呼吸困難 - 肺高血圧
#285.
診断と治療 診断 - 便または尿の鏡検:虫卵の観察 - 血液検査:抗体検査 治療 - プラジカンテル内服
#286.
予防 ワクチンなし、予防内服効果なし 住血吸虫の流行地域の淡水で泳がない 海水浴、塩素処置されたプールは安全 入浴に使用する淡水は1分以上煮沸する 貯水タンクに1~2日間保管した水は煮沸なしでも安全 汚染されている可能性のある水を飲まない(経口感染はしないが、顔面の皮膚などから感染することがある)
#287.
予防 万が一淡水曝露してしまった場合 - タオルでしっかりとふいて、乾燥させる - その後、DEET含有虫よけ剤を使用する 確実な予防法ではないが、川にあやまって落ちてしまった場合などは検討する Trans R Soc Trop Med Hyg 2003;97(4):449-450
#288.
公衆衛生における対策 リスクある地域の住民への大規模な治療 - プラジカンテルの予防的治療 - 疾患を減らすことを目的とする 安全な飲料水の利用環境の確保 衛生状況の改善 健康教育 淡水の貝の駆除 WHO. Schistosomiasis, fact sheet, 20 Feb 2018.
#289.
レプトスピラ
#290.
レプトスピラ レプトスピラ属による細菌感染症 世界中に存在する人畜共通感染症 げっ歯類などの尿や糞便から感染する 多くの場合、無症候性または軽症だが、重症化することもある 熱帯気候の雨季、温帯の夏から秋に多い
#291.
疫学 世界中に分布 特に熱帯地方 信頼性の高い疫学データが乏しい 年間100万人以上が感染し、約6万人が死亡していると推定されている PLoS Negl Trop Dis 9(9):e0003898. doi:10.1371/journal.pntd.0003898
#292.
PLoS Negl Trop Dis 9(9):e0003898. doi:10.1371/journal.pntd.0003898 東南アジア・南アジア・中南米・アフリカ
#293.
感染経路 感染したげっ歯類などの動物の糞や尿で汚染された土壌や淡水、または、直接体液を、体の傷や粘膜に接触することによって感染する ラフティング、カヤック、川や池での遊泳はリスク 汚染された食事をとることによって感染することもある ヒト-ヒト感染はほとんどない 洪水のあとにアウトブレイクが起こることがある
#294.
症状 潜伏期間:2-28日(典型的には5-14日) 発熱、頭痛、悪寒、筋肉痛、吐き気 腹痛、咳、皮疹、結膜炎 重症の場合、黄疸や腎不全、出血傾向
#295.
診断・治療 診断 - PCR(血液・尿・脳脊髄液) - 抗体検査(血液) 治療(抗菌薬) - ペニシリンG、ドキシサイクリン、セフトリアキソン
#296.
予防 裸足で歩かない(靴を履く) 淡水中を泳がない 動物の尿や便で汚染されたものを触らない 安全な水と食べものを選ぶ 食べものはしっかりと火を通す
#297.
Take Home Message 情報収集は、Googleを活用 発熱したら、熱帯熱マラリアに注意 感染症の予防には特に3つが重要 - 防蚊対策(ハエ・ダニ・ノミも) - ワクチン接種 - 食事、水に気を付ける
#298.
補足
#299.
潜伏期間の推定:例 来院 20日前 来院 3日前 来院 8日前 来院 タイ滞在 発熱 最短の潜伏期間 5日間 最長の潜伏期間 17日間 タイで感染したと仮定した場合の潜伏期間: 5-17日間
#300.